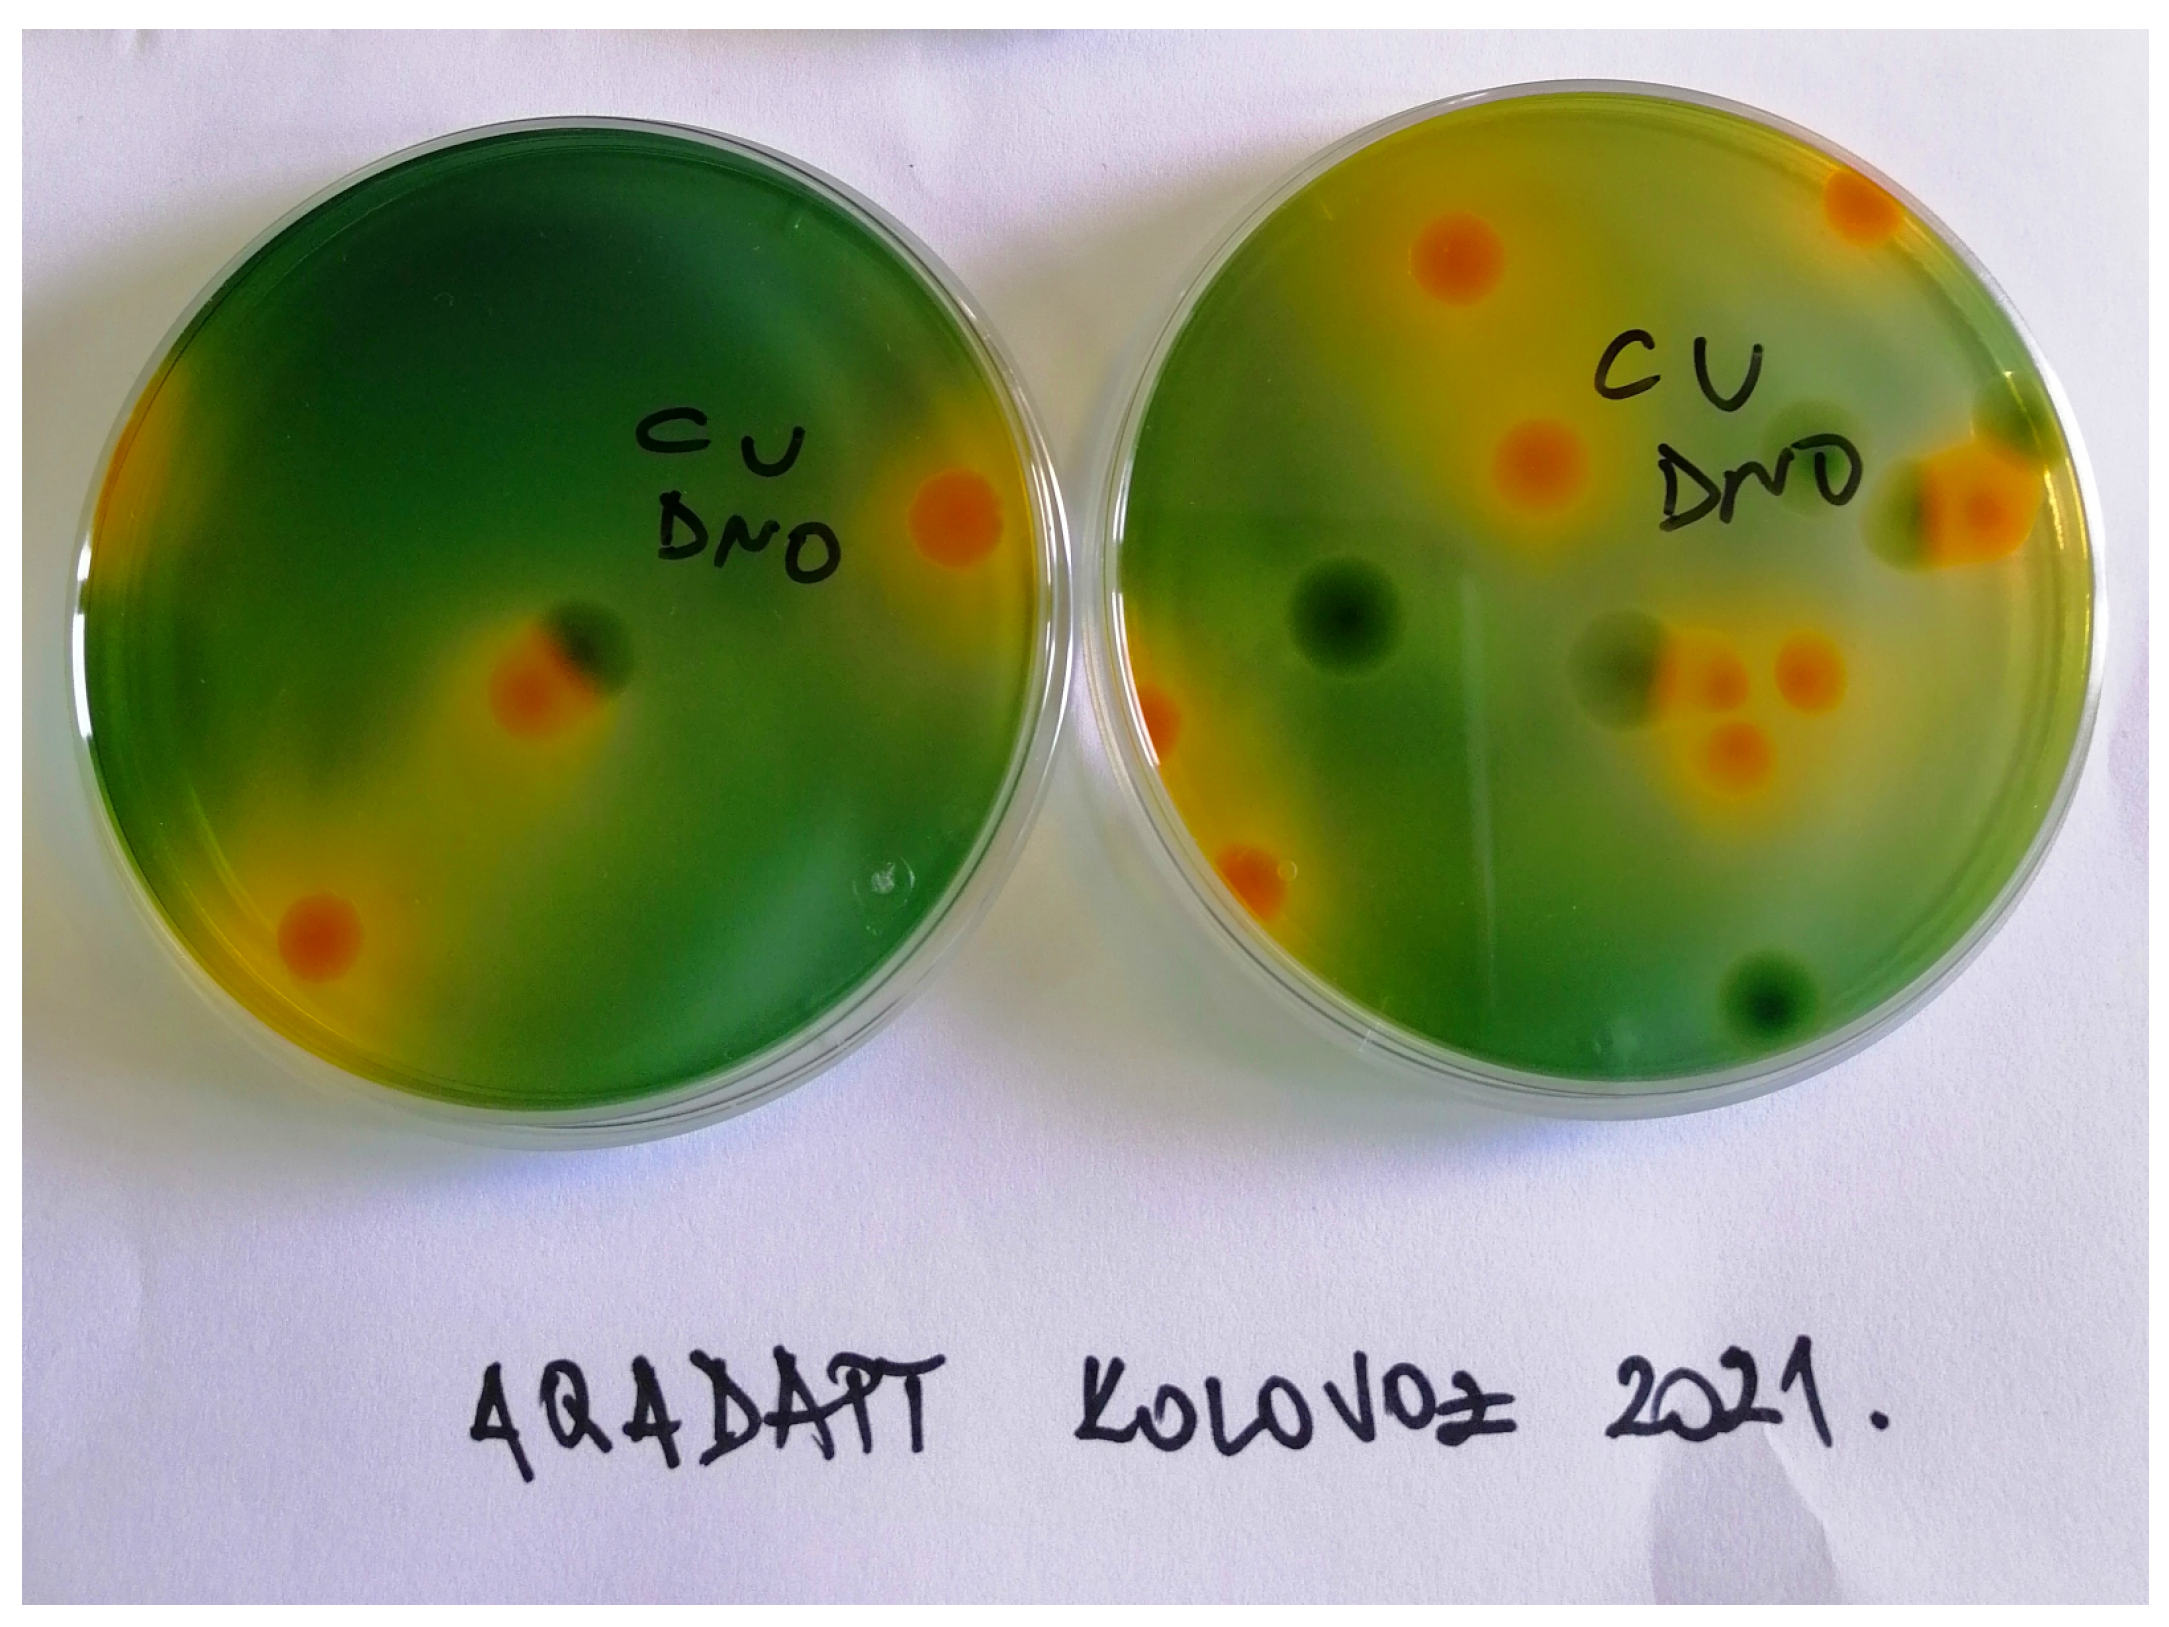
Data 08 00055 g002 Data 08 00055 g002

Abstract
Aquaculture provides more than 50% of all seafood for human consumption. This important industrial sector is already under pressure from climate-change-induced shifts in water column temperature, nutrient loads, precipitation patterns, microbial community composition, and ocean acidification, all affecting fish welfare. Disease-related risks are also shifting with important implications for risk from vibriosis, a disease that can lead to massive economic losses. Adaptation to these pressures pose numerous challenges for aquaculture producers, policy makers, and researchers. The dataset AqADAPT aims to help the development of management and adaptation tools by providing (i) measurements of physicochemical (temperature, salinity, total dissolved solids, pH, dissolved oxygen, conductivity, transparency, total nitrogen, ammonia, nitrate, nitrite, total phosphorus, total particulate matter, particulate organic matter, and particulate inorganic matter) and microbiological (heterotrophic (total) bacteria, fecal indicators, and Vibrio abundance) parameters of seawater and (ii) biochemical determination of culturable bacteria in two locations near floating cage fish farms in the Adriatic Sea. Water sampling was conducted seasonally in two fish farms (Cres and Vrgada) and corresponding reference (control) sites between 2019 and 2021 of four vertical layers for a total of 108 observations: the surface, 6 m, 12 m, and the bottom.
Data Set License: Creative Commons Attribution 4.0 International (CC-BY-4.0).
1. Introduction
The aquaculture sector is a core part of Sustainable Development Goal 14—with an important role in the conservation and sustainable use of oceans, seas, and marine resources. At present, aquaculture provides more than 50% of all seafood produced for human consumption, and by 2030, the annual production will need to reach 30 million tons to meet current consumption rates [1]. With a huge growth potential, the industry greatly affects livelihoods, employment, and local economic development among communities worldwide.
Production, especially in near-shore aquaculture, is extremely sensitive to climate change because it affects factors that determine fish survival and growth. Some of the already ongoing changes include higher sea temperatures and salinity, lower pH, microbial community shifts, and new patterns of thermocline formation [2,3,4]. Additionally, climate change contributes to the spread of infectious diseases, which are aquaculture’s largest cause of economic losses [5].
Fish health in freshwater and marine ecosystems is greatly affected by climate change, where environmental conditions, such as higher sea temperature, provide new ecological niches [6]. These, in turn, can be occupied by new species and/or change the abundance of existing, potentially pathogenic microorganisms (e.g., Vibrio spp.), which can be transferred to the fish farm areas and negatively affect production. Identifying pathogens and disease risks, as well as pathogen distribution, is essential to assess vulnerability under changing environmental conditions such as temperature, salinity, pH, etc. [6]. A general understanding of the underlying processes enables efficient monitoring and fast response to prevent epidemics [6], but our ability to capture the underlying dynamics is severely lacking [7].
Modern marine aquaculture production highly depends on the control of the microbiota in rearing systems, especially Vibrio spp. [8]. Vibrio strains are opportunistic bacterial pathogens found in aquatic systems, where they cause vibriosis—a serious infectious disease in fish, shellfish, and also in humans and other marine animals [9]. Vibrio spp. are prototypical copiotrophs that dominate in nutrient-rich environments [10] and can attach to various biotic and abiotic surfaces. This group of bacteria utilize a variety of substrates and mineralize organic matter, thus directly affecting biogeochemical processes by recycling carbon, nitrogen, and organic matter in the aquatic environment [11]. Changes in these processes can negatively affect water quality and promote adverse microbial community shifts.
This paper describes a set of recently published data on the physicochemical parameters and Vibrio spp. abundance in water samples collected in the Adriatic Sea, as well as the determination of culturable bacteria using DNA sequencing. Physicochemical parameters and Vibrio spp. abundance data have been published in the PANGAEA repository [12] as a part of the Croatian science foundation (HRZZ) project AqADAPT—Adapting Marine Finfish Aquaculture to a Changing Climate (no. IP-2018-01-3150). Additional data on heterotrophic (total) bacteria abundance and fecal indicators (total coliforms, E. coli, and enterococci) are available in the Supplementary Information of this article. Data on culturable bacteria gathered by the same project have been published in [13].
2. Materials and Methods
2.1. Study Area
The Adriatic Sea is a semienclosed sea and makes up 4.6% of the total Mediterranean Sea area [14]. It has a specific bathymetric profile which divides it into three main basins: Northern (shallow), Middle (deep), and Southern (very deep) Adriatic [15]. The position and geomorphological properties define additional Adriatic Sea specifics:
- It spans two climate areas, Mediterranean and Submediterranean, due to strong continental influence;
- The tidal range is relatively small;
- Karstic hydrogeology results in many freshwater sources underneath the surface;
- It has specific circular currents of four water masses (Northern Adriatic water of high density, Middle Adriatic water, Southern Adriatic deep water, and Levantine intermediate water);
- The river Po is a concentrated nutrient source responsible for 1/3 (>1500 m3/s) of freshwater input [16];
- It has a heterogeneous distribution of physical, chemical, and biological factors.
The varying river inputs, depths, and climate conditions result in fluctuations of the water’s physicochemical parameters, including temperature [17], thermocline formation, oxygenation, level of eutrophication (nutrient availability), water exchange, sea current regimes, sedimentation rates, etc. These factors have been shown to affect the biota of the Adriatic Sea [18,19,20,21].
2.2. Sampling Locations
Sampling was conducted in two floating-cage fish farms and two control sites in the Northern and Middle (central) Adriatic Sea (Figure 1 and Table 1), where European sea bass (Dicentrarchus labrax) and Gilthead seabream (Sparus aurata) are cultured. The farms are located in the semiopen sea at depths of about 49 m and 23 m, respectively. The control site in the Northern Adriatic was selected based on an existing reference point from the official environmental monitoring of the fish farm Orada Adriatic [22]. In the Central Adriatic, we chose an equivalent point as a control. Additional control sites would have added value to the dataset but would not affect any of the reported values.
Table 1.
Coordinates of sampling sites (Control and Fish Farm) at two locations (Cres and Vrgada).
The sampling site in the Northern Adriatic was a fish farm located on the northwest coast of the island of Cres, in the Veli Bok cove (Figure 1, upper panel). This fish farm, for the most part, is located outside the protected coastal area. The annual production capacity of the farm is 990 tons of white fish [23] with a high-quality environment in cages and sanitary conditions (low density of fish in cages and high quality of nutrition) [24]. It is “Antibiotic free”, certified by the independent auditor DNV GL Business Assurance Italia [24].
In the Central Adriatic, the sampling site was a fish farm located southeast of the island of Vrgada (Figure 1, lower panel). This farm is located outside the protected coastal area [25]. The annual production capacity of the farm is 2145 tons of fish and 220 tons of shellfish [26]. The farm, as a main preventive measure, uses fish vaccination, and only when necessary and economically feasible antibiotic disease treatment.
Figure 1.
Map of sampling locations (Cres and Vrgada) in the Adriatic Sea. Each location had two sampling sites—Control and Fish Farm. For exact coordinates of each sampling site, please see Table 1. The map was created using Datawrapper [27].
Figure 1.
Map of sampling locations (Cres and Vrgada) in the Adriatic Sea. Each location had two sampling sites—Control and Fish Farm. For exact coordinates of each sampling site, please see Table 1. The map was created using Datawrapper [27].

2.3. Sampling Methods
Samples of the water column were taken with the Niskin bottle at multiple depths (vertical layers): the surface (at approximately 50 cm), layer(s) relevant to fish habitation in aquaculture (6 m and 12 m below the surface), and demersal (approximately 50 cm above the bottom) layer. In situ measurements of water temperature, salinity, total dissolved solids (TDS), pH, dissolved oxygen, and conductivity were determined using YSI ProDSS Multiparameter Digital Water Quality Meter [28]. Vertical transparency was measured with the white Secchi disk (30 cm diameter). The limit of detection and determination of the tested water quality indicators is presented in Table S1.
2.4. Physicochemical Analysis of Water Samples
Water column samples were analyzed using physicohcemical analysis. Total nitrogen was determined by the Oxidative digestion method (ISO 11905-1:1997) with peroxodisulfate using the Hach Lange, UV/VIS spectrophotometer DR/6000. The same spectrophotometer and the following Hach methods for Water Analysis [29] were used to measure the concentration of:
- Nitrates ()—Hach method 8192;
- Nitrites ()—Hach method 8507;
- Ammonia ()—Hach method 10023;
- Total phosphorus (P)—Hach method LCK348.
Particulate matter analyses were performed in triplicates, where 1-L aliquot samples were filtered onto preashed (3 h at 450 °C) 47 mm GF/C filters (Whatman). Total particulate matter (TPM), particulate organic matter (POM), and particulate inorganic matter (PIM) was determined according to the method described in [30].
2.5. Microbiological Analysis of Water Samples
Total coliform bacteria and E. coli in the seawater samples was counted by a defined substrate technology using Colilert-18 (IDEXX, Westbrook, ME, USA); enterococci were counted by Enterolert-E (IDEXX). The total of coliforms, E. coli, and enterococci was enumerated using Quantitray2000 (IDEXX), which provides the most probable numbers (MPN/100 mL). Enumeration of heterotrophic bacteria (HPC) was performed using serially diluted seawater samples which were spread on Difco™ Marine Agar 2216 BD (BD, Sparks, MD, USA), and the plates were incubated at 22 °C for 24 h and 3–5 days.
2.6. Vibrio spp. and Biochemical Analysis
Vibrio spp. abundance from water samples was determined by counting the total number of visible colonies that exhibited relief from the plate surface from the Thiosulphate Citrate Bile Salt Sucrose (TCBS) (Difco™, Becton, Dickinson and Company) agar plates (Figure 2). Mass spectrometer MALDI-TOF Biotyper (Bruker Daltonik) was used for bacterial identification. For a detailed description of DNA Isolation and PCR Amplification of Partial 16S rRNA Gene and Sequencing and Phylogenetic Analysis of Vibrio spp., please refer to [13].
Figure 2.
Visible colonies that exhibited relief from the plate surface from the Thiosulphate Citrate Bile Salt Sucrose (TCBS) (Difco™, Becton, Dickinson and Company) agar plates when determining Vibrio spp. abundance from the water samples gathered at Cres—Fish Farm on Bottom depth in August 2021.
Dataset analysis was performed in RStudio Integrated Development Environment [31], Version 4.2.2, using package ‘tidyverse’ [32]. We visualized results using the package ‘ggplot2’ [33].
3. Data Description
Dataset AqADAPT is comprised of five categorical variables: Date (sampling dates), Location (Vrgada—Fish Farm, Vrgada—Control, Cres—Fish Farm, and Cres—Control), Depth (surface, 6 m, 12 m, and bottom), Season (Spring, Summer, Autumn, and Winter), and Fecal indicators (total coliforms, E. coli, and enterococci), along with 17 numerical variables (Figure 3). Measured abundances of heterotrophic (total) bacteria and Fecal indicators (total coliforms, E. coli, and enterococci) are provided in the Supplementary Information of this article (Table S2).
Figure 3.
Categorical and numerical variables of AqADAPT dataset. Numerical variables are categorized as follows: In situ measurements, laboratory analysis, heterotrophic (total) bacteria, and Vibrio spp. analysis. All numerical variables and fecal indicator variables include the corresponding units of measurement.
Numerical variables listed in Table 2 describe physicochemical parameters (temperature, salinity, TDS, pH, , conductivity, transparency, P, N, , , , TPM, POM, and PIM), heterotrophic (total) bacteria, and Vibrio abundance measured in sampling locations. Additionally, Table 3 and Table 4 summarize the descriptive statistics of the aforementioned variables in the AqADAPT dataset based on the sampling locations Cres and Vrgada, respectively.
Table 2.
Numerical variables (17) measured in both locations and at four depths (surface, 6 m, 12 m, and bottom). Information on each numerical variable is summarized as follows: Min—minimum value, 1st Qu.—first quartile, Median—median value, Mean—mean value, 3rd Qu.—third quartile, Max—maximum value, N—number of samples, and NA—not available. Fecal indicators (total coliforms, E. coli, and enterococci) are categorical variables and therefore cannot be included in this table; please see Table S2.
Table 3.
Numerical variables (17) measured in Cres (Control and Fish Farm) at four depths (surface, 6 m, 12 m, and bottom). Information on each numerical variable is summarized as follows: Min—minimum value, 1st Qu.—first quartile, Median—median value, Mean—mean value, 3rd Qu.—third quartile, Max—maximum value, N—number of samples, and NA—not available. Fecal indicators (total coliforms, E. coli, and enterococci) are categorical variables and therefore cannot be included in this table; please see Table S2.
Table 4.
Numerical variables (17) measured in Vrgada (Control and Fish Farm) at four depths (surface, 6 m, 12 m, and bottom). Information on each numerical variable is summarized as follows: Min—minimum value, 1st Qu.—first quartile, Median—median value, Mean—mean value, 3rd Qu.—third quartile, Max—maximum value, N—number of samples, and NA—not available. Fecal indicators (total coliforms, E. coli, and enterococci) are categorical variables and therefore cannot be included in this table; please see Table S2.
Vibrio abundance was successfully determined for all water samples (n = 108) collected at different sampling depths. Figure 4 shows the distribution of Vibrio abundance through seasonal measurements. Bacterial abundance varied with seasons, and the highest values were measured in autumn and winter.
Figure 4.
Vibrio abundance (CFU/mL) measured in water samples in four different locations (Cres—Control, Cres—Fish Farm, Vrgada—Control, and Vrgada—Fish Farm) and four water sampling depths (surface, 6 m, 12 m, and bottom) that are color-labeled.
Based on the microbiological analyses of swab samples from sea bass (Dicentrarchus labrax) grown at two farms, the presence of bacteria of the genus Vibrio was determined at both farms. Among the identification results based on MALDI TOF analysis, the most numerous isolates (80%) were: V. gigantis, V. harveyi, V. pomeroyi, V. chagasii, and V. tasmaniensis. A smaller part (20%) of the isolates consisted of V. alginolyticus, V. anguillarum, V. toranzoniae, V. tubiashii, V. kanaloae, and V. cyclitrophicus. For more details, please refer to [13], Tables S3 and S4.
The 16S rRNA gene sequences were generated for 81 and 64 bacterial isolates from Cres—Fish Farm and Vrgada—Fish Farm, respectively [13]. The isolates were labeled based on the sample type: skin swabs of European seabass, seawater, and sediment (Tables S3 and S4). Based on the sequence comparison:
- Thirty-three bacterial species were identified among the isolates from the Cres—Fish Farm;
- Twenty-two bacterial species were identified among the isolates from all the sample types in the Vrgada—Fish Farm.
Results of molecular identification from the antibiotic-free farm (Cres—Fish Farm) and from the conventional farm (Vrgada—Fish Farm) that uses vaccination of early juveniles as a main preventive measure against most pathogenic Vibrio spp. are also available in [13].
4. User Notes
The AqADAPT dataset contains measurements of physicochemical and microbiological parameters of seawater and determined culturable bacteria in two sites in the Adriatic Sea. The main motivations behind our paper are encouraged data sharing practices, and reuse of data in all phases of the data lifecycle: generating and collecting the data, managing the data, analyzing the data, and finally, sharing it [34]. The given dataset may serve to augment existing data collections and can be used for knowledge synthesis (e.g., meta-analysis), model parameterization, and validation of research findings.
Given the challenges imposed by climate change, investigating current environmental patterns is crucial in providing clues on how future conditions can be intercepted. The AqADAPT dataset contains information on Vibrio abundance that could help: (1) in assessing the threat of vibriosis outbreaks in aquaculture, (2) to investigate the pathogen dynamics and strategies for preventing adverse effects, and (3) to determine and/or compare microbial community shifts.
The AqADAPT dataset was already used in assessing the ability of different bacterial growth models to predict the Vibrio spp. abundance, as published in [7]. The research emphasizes the need for model improvement, as the models underperformed in environments under significant anthropogenic influence. Additionally, improved models can advance predictive frameworks applied in the assessment of future risk scenarios, as can be seen in [35].
Measured physicochemical and microbiological parameters are crucial to identify the most significant correlations between fish health disorders and quality of water, and they are also necessary for the prediction of the influence of climate change on fish health. Results of DNA sequencing can help with determining potential antibiotic resistance, which is pivotal information for aquaculture production worldwide.
Supplementary Materials
The following supporting information can be downloaded at: https://www.mdpi.com/article/10.3390/data8030055/s1. Table S1: Limit of detection and determination of the tested water quality indicators; Table S2: Measured abundances of: heterotrophic (total) bacteria (HPC), total coliforms (TC), E. coli, and enterococci for each sampling site (Cres—Control, Cres—Fish Farm, Vrgada—Control and Vrgada—Fish Farm; Table S3: Results of molecular identification of bacterial isolates from the Cres—Fish Farm (Ramljak et al. 2022); Table S4: Results of molecular identification of bacterial isolates from the Vrgada—Fish Farm (Ramljak et al. 2022). References [13,30] are cited in the supplementary materials.
Author Contributions
Conceptualization, T.K.; methodology, T.K.; writing—original draft preparation, M.P. and T.K.; data acquisition, A.G., D.K., B.K., J.Ž., F.B., T.D., D.K.H. and B.K.H.; formal analysis, D.K., A.G., F.B. and Z.Š.V.; writing—review and editing, all authors; visualization, M.P., D.K. and T.K.; supervision, T.K. All authors have read and agreed to the published version of the manuscript.
Funding
This research was funded by the Croatian Science Foundation (HRZZ) project AqADAPT (no. IP-2018-01-3150 to T.K. and DOK-2021-02-6688 to T.K. for M.P.).
Data Availability Statement
The AqADAPT dataset can be accessed and shared via PANGAEA repository [12] and Supplementary Information of this article.
Acknowledgments
We thank Kornat-Ittica d.o.o.(Pakoštane, Croatia) and Orada Adriatic d.o.o. (Cres, Croatia) for access to sampling sites and free use of equipment, materials, and labor in sampling.
Conflicts of Interest
The authors declare no conflict of interest.
References
- FAO. The State of World Fisheries and Aquaculture 2020. Sustainability in Action; Food and Agriculture Organization of the United Nations: Rome, Italy, 2020. [Google Scholar] [CrossRef]
- Poloczanska, E.S.; Brown, C.J.; Sydeman, W.J.; Kiessling, W.; Schoeman, D.S.; Moore, P.J.; Brander, K.; Bruno, J.F.; Buckley, L.B.; Burrows, M.T.; et al. Global imprint of climate change on marine life. Nat. Clim. Change 2013, 3, 919–925. [Google Scholar] [CrossRef]
- Dore, M.H. Climate change and changes in global precipitation patterns: What do we know? Environ. Int. 2005, 31, 1167–1181. [Google Scholar] [CrossRef] [PubMed]
- Bijma, J.; Pörtner, H.O.; Yesson, C.; Rogers, A.D. Climate change and the oceans–What does the future hold? Mar. Pollut. Bull. 2013, 74, 495–505. [Google Scholar] [CrossRef]
- Meyer, F.P. Aquaculture disease and health management. J. Anim. Sci. 1991, 69, 4201–4208. [Google Scholar] [CrossRef]
- Marcogliese, D. The impact of climate change on the parasites and infectious diseases of aquatic animals. Rev. Sci. Tech. 2008, 27, 467–484. [Google Scholar] [CrossRef]
- Purgar, M.; Kapetanović, D.; Geček, S.; Marn, N.; Haberle, I.; Hackenberger, B.K.; Gavrilović, A.; Pečar Ilić, J.; Hackenberger, D.K.; Djerdj, T.; et al. Investigating the Ability of Growth Models to Predict In Situ Vibrio spp. Abundances. Microorganisms 2022, 10, 1765. [Google Scholar] [CrossRef]
- Olafsen, J.A. Interactions between fish larvae and bacteria in marine aquaculture. Aquaculture 2001, 200, 223–247. [Google Scholar] [CrossRef]
- Sampaio, A.; Silva, V.; Poeta, P.; Aonofriesei, F. Vibrio spp.: Life strategies, ecology, and risks in a changing environment. Diversity 2022, 14, 97. [Google Scholar] [CrossRef]
- Kirchman, D.L. Growth rates of microbes in the oceans. Annu. Rev. Mar. Sci. 2016, 8, 285–309. [Google Scholar] [CrossRef]
- Zhang, X.; Lin, H.; Wang, X.; Austin, B. Significance of Vibrio species in the marine organic carbon cycle—A review. Sci. China Earth Sci. 2018, 61, 1357–1368. [Google Scholar] [CrossRef]
- Kapetanović, D.; Gavrilović, A.; Purgar, M.; Hackenberger, B.K.; Kurtović, B.; Haberle, I.; Pečar Ilić, J.; Geček, S.; Hackenberger, D.K.; Djerdj, T.; et al. Physicochemical parameters and Vibrio spp. abundance in water samples gathered in the Adriatic Sea [dataset]. PANGAEA, 2022; epub ahead of print. [Google Scholar] [CrossRef]
- Ramljak, A.; Vardić Smrzlić, I.; Kapetanović, D.; Barac, F.; Kolda, A.; Perić, L.; Balenović, I.; Klanjšček, T.; Gavrilović, A. Skin Culturable Microbiota in Farmed European Seabass (Dicentrarchus labrax) in Two Aquacultures with and without Antibiotic Use. J. Mar. Sci. Eng. 2022, 10, 303. [Google Scholar] [CrossRef]
- Viličić, D. Specific oceanological characteristics of the Croatian part of the Adriatic Sea. Hrvat. Vode Časopis Vodn. Gospod. 2014, 90, 297–314. [Google Scholar]
- Russo, A.; Artegiani, A. Adriatic sea hydrography. Sci. Mar. 1996, 60, 33–43. [Google Scholar]
- Barale, V.; McClain, C.R.; Malanotte-Rizzoli, P. Space and time variability of the surface color field in the northern Adriatic Sea. J. Geophys. Res. Ocean. 1986, 91, 12957–12974. [Google Scholar] [CrossRef]
- Gačić, M.; Marullo, S.; Santoleri, R.; Bergamasco, A. Analysis of the seasonal and interannual variability of the sea surface temperature field in the Adriatic Sea from AVHRR data (1984–1992). J. Geophys. Res. Ocean. 1997, 102, 22937–22946. [Google Scholar] [CrossRef]
- Dulčić, J.; Grbec, B.; Lipej, L.; Paklar, G.B.; Supić, N.; Smirčić, A. The effect of the hemispheric climatic oscillations on the Adriatic ichthyofauna. Fresenius Environ. Bull. 2004, 13, 293–298. [Google Scholar]
- Dulčić, J.; Paklar, G.B.; Grbec, B.; Morović, M.; Matić, F.; Lipej, L. On the occurrence of ocean sunfish Mola mola and slender sunfish Ranzania laevis in the Adriatic Sea. J. Mar. Biol. Assoc. 2007, 87, 789–796. [Google Scholar] [CrossRef]
- Grbec, B.; Morović, M.; Paklar, G.B.; Kušpilić, G.; Matijević, S.; Matić, F.; Gladan, Ž.N. The relationship between the atmospheric variability and productivity in the Adriatic Sea area. J. Mar. Biol. Assoc. 2009, 89, 1549–1558. [Google Scholar] [CrossRef]
- Ninčević Gladan, Ž.; Marasović, I.; Grbec, B.; Skejić, S.; Bužančić, M.; Kušpilić, G.; Matijević, S.; Matić, F. Inter-decadal variability in phytoplankton community in the Middle Adriatic (Kaštela Bay) in relation to the North Atlantic Oscillation. Estuaries Coasts 2010, 33, 376–383. [Google Scholar] [CrossRef]
- Cukrov, N.; Bulat, T.; Lovrić, M.; Omanović, D. Monitoring of the Environment of the Fish Farm Orada Adriatic; Ruđer Bošković Institute: Zagreb, Croatia, 2019. [Google Scholar]
- The Decision of The Ministry of Environment and Energy of the Republic of Croatia. 2015. Available online: https://mingor.gov.hr/UserDocsImages/ARHIVA%20DOKUMENATA/ARHIVA%20—%20OPUO/2015/30042015_-_rjesenje_ministarstva_od_29_travnja_2015_godine.pdf (accessed on 14 September 2022).
- Orada Adriatic Granted ANTIBIOTIC FREE Certificate for All of Its Farms! Available online: https://royal-adriatic.com/news/orada-adriatic-granted-antibiotic-free-certificate-for-all-of-its-farms (accessed on 14 September 2022).
- The Decision of The Ministry of Construction, Spatial Planning and State Property of the Republic of Croatia. 2016. Available online: https://mmpi.gov.hr/UserDocsImages/arhiva/Prilog2-I-IzmjeneIDopuneLokacijskeDozvole.pdf (accessed on 14 September 2022).
- The Decision of Zadar County of the Republic of Croatia. 2015. Available online: https://zadarska-zupanija.hr/kolegij2015/36/13.1.pdf (accessed on 14 September 2022).
- Datawrapper. Available online: https://app.datawrapper.de/ (accessed on 16 September 2022).
- ProDSS Multiparameter Digital Water Quality Meter. Available online: https://www.ysi.com/prodss (accessed on 14 September 2022).
- Water Analysis Handbook. Available online: https://www.hach.com/wah (accessed on 19 September 2022).
- Paterson, K.J.; Schreider, M.J.; Zimmerman, K.D. Anthropogenic effects on seston quality and quantity and the growth and survival of Sydney rock oyster (Saccostrea glomerata) in two estuaries in NSW, Australia. Aquaculture 2003, 221, 407–426. [Google Scholar] [CrossRef]
- RStudio Team. RStudio: Integrated Development Environment for R; RStudio, PBC.: Boston, MA, USA, 2020. [Google Scholar]
- Wickham, H.; Averick, M.; Bryan, J.; Chang, W.; McGowan, L.D.; François, R.; Grolemund, G.; Hayes, A.; Henry, L.; Hester, J.; et al. Welcome to the tidyverse. J. Open Source Softw. 2019, 4, 1686. [Google Scholar] [CrossRef]
- Wickham, H. ggplot2: Elegant Graphics for Data Analysis; Springer: New York, NY, USA, 2016. [Google Scholar]
- Tenopir, C.; Allard, S.; Douglass, K.; Aydinoglu, A.U.; Wu, L.; Read, E.; Manoff, M.; Frame, M. Data sharing by scientists: Practices and perceptions. PLoS ONE 2011, 6, e21101. [Google Scholar] [CrossRef] [PubMed]
- Trinanes, J.; Martinez-Urtaza, J. Future scenarios of risk of Vibrio infections in a warming planet: A global mapping study. Lancet Planet. Health 2021, 5, e426–e435. [Google Scholar] [CrossRef] [PubMed]
Disclaimer/Publisher’s Note: The statements, opinions and data contained in all publications are solely those of the individual author(s) and contributor(s) and not of MDPI and/or the editor(s). MDPI and/or the editor(s) disclaim responsibility for any injury to people or property resulting from any ideas, methods, instructions or products referred to in the content. |
© 2023 by the authors. Licensee MDPI, Basel, Switzerland. This article is an open access article distributed under the terms and conditions of the Creative Commons Attribution (CC BY) license (https://creativecommons.org/licenses/by/4.0/).